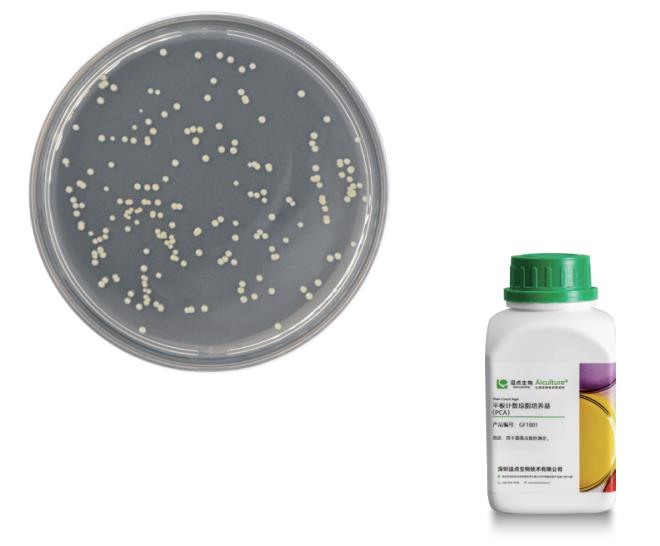
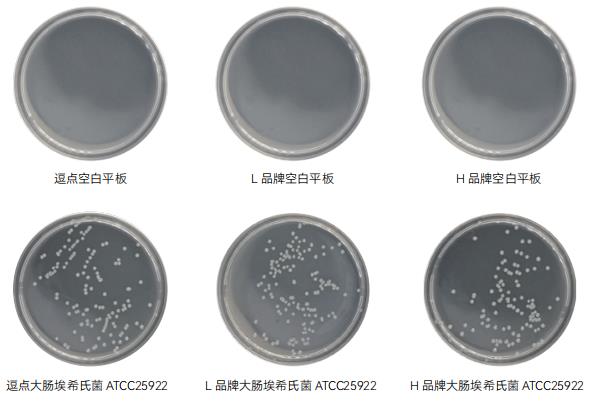
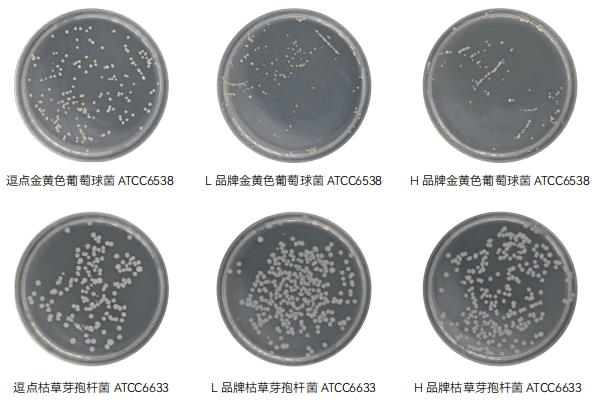

7:在培养箱中倒置培养,为防止中间平皿过热,堆叠高度建议不超过 5 个平皿。
2. 结果计数
•可用肉眼观察 , 必要时用放大镜或菌落计数器 , 记录稀释倍数和相应的菌落数量。菌落计数以菌落形成单位 (colony-formingunits,CFU) 表示。
•选取菌落数在 30CFU~300CFU 之间、无蔓延菌落生长的平板计数菌落总数。低于30CFU的平板记录具体菌落数,大于300CFU的可记录为多不可计。每个稀释度的菌落数应采用两个平板的平均数。
•其中一个平板有较大片状菌落生长时 , 则不宜采用 , 而应以无片状菌落生长的平板作为该稀释度的菌落数 ; 若片状菌落不到平板的一半 , 而其余一半中菌落分布又很均匀 , 即可计算半个平板后乘以 2, 代表一个平板菌落数。
•当平板上出现菌落间无明显界线的链状生长时,则将每条单链作为一个菌落计数。

3. 结果计算
•若只有一个稀释度平板上的菌落数在 30~300CFU 之间 , 计算两个平板菌落数的平均值 , 再将平均值乘以相应稀 释倍数 , 作为每 g(mL) 样品中菌落总数结果。
•若所有稀释度的平板上菌落数均大于 300CFU, 则对稀释度最高的平板进行计数 , 其他平板可记录为多不可计 , 结 果按平均菌落数乘以最高稀释倍数计算。
•若所有稀释度的平板菌落数均小于 30CFU, 则应按稀释度最低的平均菌落数乘以稀释倍数计算。
•若所有稀释度 ( 包括液体样品原液 ) 平板均无菌落生长 , 则以小于 1 乘以最低稀释倍数计算。
•若所有稀释度的平板菌落数均不在 30CFU~300CFU 之间 , 其中一部分小于 30CFU 或大于 300CFU 时 , 则以最接 近 30CFU 或 300CFU 的平均菌落数乘以稀释倍数计算。
•若有两个连续稀释度的平板菌落数在适宜计数范围内时 , 按式 (1) 计算 :
4. 结果报告
•菌落数小于 100CFU 时 , 按 “四舍五入” 原则修约 , 以整数报告。
•菌落数大于或等于 100CFU 时 , 第 3 位数字采用 “四舍五入” 原则修约后 , 取前 2 位数字 , 后面用 0 代替位数 ; 也可用 10 的指数形式来表示 , 按 “四舍五入” 原则修约后 , 采用两位有效数字。
•若所有平板上为蔓延菌落而无法计数 , 则报告菌落蔓延。
•若空白对照上有菌落生长 , 则此次检测结果无效。
•称重取样以 CFU/g 为单位报告 , 体积取样以。CFU/mL 为单位报告。
•注:菌落总数结果计算与报告方式实例见以下表格
编号 |
稀释倍数及菌落数 |
|
|
| 10-1 |
10-2 |
10-3 |
菌落总数 |
报告方式 |
| 平皿 1 |
平皿 2 |
平皿 1 |
平皿 2 |
平皿 1 |
平皿 2 |
(CFU/g 或 CFU/mL) |
(CFU/g 或 CFU/mL) |
| 1 |
0 |
0 |
0 |
0 |
0 |
0 |
﹤1×10 |
﹤10 |
| 2 |
24 |
26 |
5 |
7 |
0 |
0 |
250 |
250 或 2.5×102 |
| 3 |
多不可计 |
多不可计 |
150 |
160 |
15 |
20 |
15500 |
16000 或 1.6×104 |
| 4 |
多不可计 |
多不可计 |
236 |
245 |
35 |
33 |
24955 |
25000 或 2.5×104 |
| 5 |
多不可计 |
多不可计 |
236 |
245 |
25 |
33 |
24476 |
24000 或 2.4×104 |
| 6 |
多不可计 |
多不可计 |
多不可计 |
多不可计 |
320 |
330 |
325000 |
330000 或 3.3×105 |
| 7 |
多不可计 |
多不可计 |
310 |
320 |
28 |
26 |
27000 |
27000 或 2.7×104 |
| 8 |
多不可计 |
多不可计 |
295 |
325 |
22 |
20 |
29500 |
30000 或 3.0×104 |
| 9 |
菌落蔓延 |
菌落蔓延 |
菌落蔓延 |
菌落蔓延 |
菌落蔓延 |
菌落蔓延 |
菌落蔓延 |
菌落蔓延 |
三、质量控制和疑难解析
1. 质量控制
•实验室过程中,每批样品稀释液都要做空白对照。
•为了控制环境污染,每次检验过程中,于检验台上打开两块计数琼脂平板,并在检验环境中暴露不少于 15 分钟,将此平板与本批次样品同时进行培养,以掌握检验过程中是否存在来自检验环境的污染。
•定期使用大肠埃希氏菌 ATCC25922、金黄色葡萄球菌 ATCC6538 和枯草芽孢杆菌 ATCC6633 或相应定量活菌参考品,在 P2 实验室或阳性对照实验室内,用适当的食品样品进行阳性实验验证,并进行记录,次验证实验至少每 2 个月进行 1 次。
2. 疑难解析
1:为什么水产品与其他食品中菌落总数检测时所采用的培养条件不同?
水产品产自海水或淡水,其温度较低,因而在制定水产品的食品安全检验时选择了 30±1℃进行培养,培养时间为 72±3h。
2:当高稀释度平板上的菌落数反而比低稀释度平板上菌落数高时,如何处理?
首先结果不能直接记录报告。应针对此结果进行原因分析,并对剩余样品进行重复实验,如确认结果如此,则表示样品中可能有影响菌落计数结果的抑菌物质,应使用稀释、中和剂、过滤等方式去除样品中的抑菌物质再进行检测、报告。
3:当所有平板上都菌落密布时,结果如何报告?
不应报告多不可计,应在稀释度最高的两个平板上,分别任意取 2cm2, 计数其中的菌落数,计算每 2cm2 的平均菌落数,乘以平皿面积(如平皿直径为 90mm, 则乘以平皿面积 63.6cm2),再乘以稀释倍数报告。
四、所需培养基试剂
| 用途 |
货号 |
名称 |
规格 |
样品稀释 |
DZ1000.225 |
生理盐水 |
盒(袋装)225 mL×10 袋 |
| PZ1000.225 |
0.85% 生理盐水(瓶装即用型) |
225mL/ 瓶 ×10 |
| GZ1011.9 |
磷酸盐缓冲液(PBS) |
盒(管装)9 mL×20 支 |
| GZ1011.10 |
磷酸盐缓冲液(PBS) |
盒(管装)10 mL×20 支 |
| GF1011 |
磷酸盐缓冲液(PBS) |
瓶(干粉)250 g |
| GZ1000.9 |
生理盐水 |
盒(管装)9 mL×20 支 |
平板计数 |
GF1001 |
平板计数琼脂(PCA) |
瓶(干粉)250 g |
| GF1001-1KG |
平板计数琼脂(PCA) |
瓶(干粉)1000g |
| KL1001 |
平板计数琼脂 ( 颗粒型 )(PCA) |
瓶(颗粒)250 g |
| KL1001-1KG |
板计数琼脂 ( 颗粒型 )(PCA) |
瓶(颗粒)1000 g |
| 微生物测试片 |
TS001 |
菌落总数测试片 |
25 片 / 包 |
平板计数琼脂(PCA)
1、产品用途:用于菌落总数测定。
2、检验原理:胰蛋白胨提供碳源和氮源;酵母膏粉提供 B 族维生素;葡萄糖提供能源;琼脂是培养基的凝固剂。
3、平板计数琼脂(PCA)验证

| 样品名称 |
质控菌株 |
厂家 |
待测培养基计数 |
参比培养基计数(TSA) |
生长率(或特征) |
评定标准 |
结果判定 |
平板 计数 琼脂 (PCA) |
大肠埃
希氏菌
ATCC25922 |
逗点 |
115 |
142 |
0.8 |
逗点 |
符合 |
| L 品牌 |
138 |
| 0.9 |
L 品牌 |
符合 |
| H 品牌 |
121 |
0.8 |
H 品牌 |
符合 |
| 金黄色 葡萄球菌 ATCC6538 |
逗点 |
202 |
155 |
1.3 |
逗点 |
符合 |
| L 品牌 |
180 |
1.1 |
L 品牌 |
符合 |
| H 品牌 |
131 |
0.8 |
H 品牌 |
符合 |
枯草芽
孢杆菌 ATCC6633 |
逗点 |
219 |
187 |
1.1 |
逗点 |
符合 |
| L 品牌 |
281 |
1.5 |
L 品牌 |
符合 |
| H 品牌 |
230 |
1.2 |
H 品牌 |
符合 |
4、典型特征图片:


5、验证结果小结:
1、生长率:目标菌大肠埃希氏菌 ATCC25922 、金黄色葡萄球菌 ATCC6538、枯草芽孢杆菌 ATCC6633,逗点、L 品牌、H 品牌均满足国标 PR≥0.7 的要求。
2、感观:三家平板颜色无显著差异。